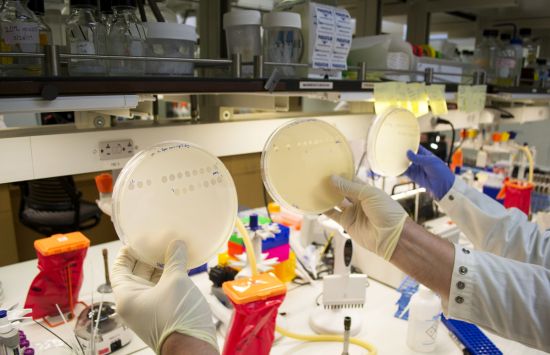
Lab of professor Justin Meyer

The U.S. National Science Foundation supports research on emerging infectious diseases through cross-disciplinary efforts spanning biological, physical and social sciences and engineering. This research aims to predict, detect and mitigate disease — be it in plants, non-human animals, or humans — by developing new therapeutics, detection methods and preventative measures, safeguarding public health and economic stability.
 On this page
On this page
What we support

Fundamental research
NSF-supported research on emerging infectious diseases cuts across areas of science and engineering, including understanding the science of transmission, modeling disease spread, and evaluating and mitigating the impact on society.

Education and workforce development
NSF supports the creation of a highly skilled workforce ready to design, implement and manage innovative solutions to understand, track, and mitigate emerging infectious diseases.

Partnerships and collaboration
NSF partners with other federal agencies, industry and nonprofits to advance research on emerging infectious diseases and spurs collaborations among NSF-funded researchers to achieve the interdisciplinarity critical to this area of research.
Featured funding

Biological Sciences
Supports innovative research infrastructure, computational tools and training programs that enhance the ability to predict, understand and respond to infectious diseases at all levels.
Learn more about the Division of Biological Infrastructure.
Supports research and training on evolutionary and ecological processes acting at the level of populations, species, communities, ecosystems, macrosystems and biogeographic extents.
Learn more about the Division of Environmental Biology.
Supports research focused on host-pathogen interactions, the impact of infections on physiological and behavioral processes and the evolutionary development of immune systems, with a particular emphasis on integrative and systems-based approaches.
Learn more about the Division of Integrative Organismal Systems.
Supports emerging infectious disease research by funding investigations into pathogen behavior at molecular, subcellular and cellular levels using laboratory, modeling and computational methods.
Learn more about the Division of Molecular and Cellular Biosciences.

Computer and Information Sciences and Engineering
Supports research at the intersection of computing and biological systems, nanoscale science and engineering, quantum information science and other technologies that promote novel computing and communication models.
Learn more about the Foundations of Emerging Technologies Cluster.
Supports computational research on the full data life cycle, from collection through archiving, analysis and discovery, to maximize the utility of information resources for science and engineering.
Learn more about the IIS: Information Integration and Informatics program.

Mathematical and Physical Sciences
Supports fundamental research in developing new chemical tools for detecting and understanding bacterial and viral infections, as well as strategies to combat emerging infectious diseases and pandemics.
Learn more about the Division of Chemistry.
Supports research to develop innovative measurement and imaging techniques for chemical, biological and material systems to advance understanding across a range of scientific fields.
Learn more about Chemical Measurement and Imaging.
Supports experimental and computational research that uses innovations in chemistry to study the molecular underpinnings of biological processes.
Learn more about Chemistry of Life Processes.
Supports research focused on developing innovative methods for the synthesis of new and existing molecules with broad applications in chemistry, biology and materials science.
Learn more about Chemical Synthesis.
Supports research in mathematical modeling of emerging and re-emerging infectious diseases, often through interdisciplinary collaborations. Key areas include forecasting disease outbreaks, understanding pathogen evolution and integrating human social and behavioral factors into epidemiological models.
Learn more about the Mathematical Biology program.
Administers NSF-wide STEM research programs, prestigious honorary awards and STEM talent development programs.
Learn more about Integrative Activities.

Technology, Innovation and Partnerships
Supports interdisciplinary research and development teams working to advance innovative solutions to complex societal challenges by bridging fundamental research and practical applications.
Learn more about Convergence Accelerator.
Supports regional economic growth and innovation by fostering collaboration among local stakeholders to address key challenges and leverage unique regional strengths.
Learn more about Regional Innovation Engines.
Supports the facilitation, creation and growth of open-source ecosystems for creating of new technological solutions.
Learn more about Pathways to Enable Open-Source Ecosystems.
Supports the commercialization of research by helping scientists and engineers translate their innovations into market-ready technologies through mentorship and industry partnerships.
Learn more about NSF Innovation Corps (I-Corps™).
Supports early-stage startups developing advanced technologies with potential for societal or commercial impact by providing funding to translate scientific discoveries into marketable solutions.
Learn more about America’s Seed Fund, powered by NSF.
Cross-directorate and NSF-wide programs
Supports the development of transformative advances in computer and information science, engineering, mathematics, statistics, behavioral and cognitive research to address pressing questions in the biomedical and public health communities.
Learn more about Smart Health and Biomedical Research in the Era of Artificial Intelligence and Advanced Data Science.
Supports efforts to enhance research capacity and infrastructure in underfunded states, aiming to build competitive, sustainable science and engineering research environments.
Learn more about the NSF Established Program to Stimulate Competitive Research (EPSCoR) program.


